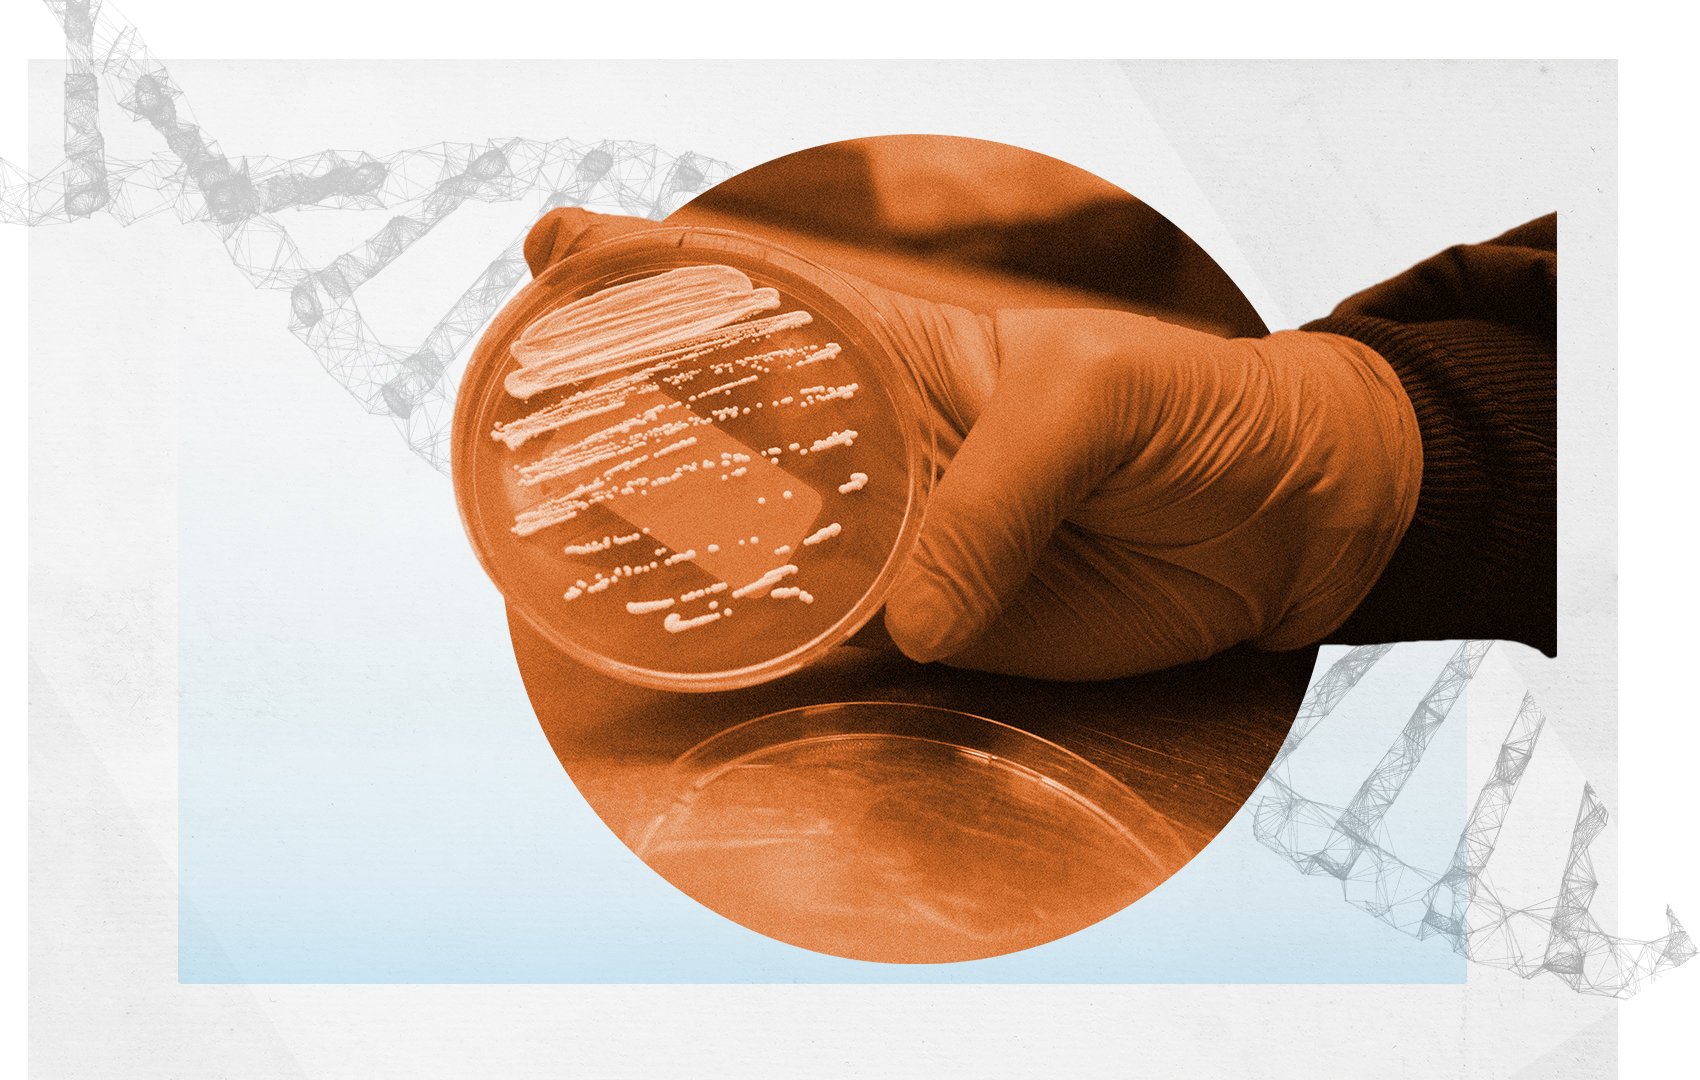
ModiGen_BG_02-2

Yeast Management: How the Best Brewers Think Through Fermentation
Professional brewers are natural problem-solvers. Every brew day presents dozens of small decisions, grain bill adjustments, hop timing, tank scheduling, fermentation temperatures. Most of those decisions are based on experience, observation, and one simple question: “What variables actually matter here?” When it comes to fermentation, the breweries that produce the most consistent beer don’t just…
Read more